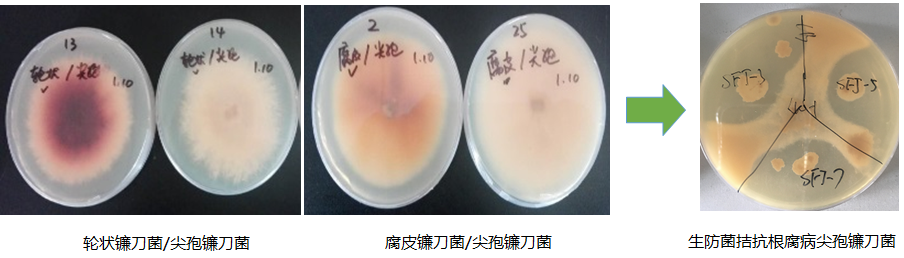

微生物復(fù)合菌劑的開(kāi)發(fā)與應(yīng)用,從種植地土壤中篩選分離功能性菌株,其具有促進(jìn)生長(zhǎng)、土壤改良、生物防治等功能,通過(guò)液體、固體發(fā)酵,進(jìn)行微生物復(fù)合菌劑/肥的技術(shù)研發(fā)、大田試驗(yàn)及應(yīng)用推廣。大田試驗(yàn)表明,使用專用功能性微生物菌肥,能促進(jìn)作物生長(zhǎng),提高抗病害能力,還可提升作物的品質(zhì)及產(chǎn)量,平均增產(chǎn)15%左右。還可明顯改善土壤肥力,增加土壤微生物多樣性,有效提升耕地質(zhì)量。
微生物菌肥或菌劑作為一種新型肥料,在提高化肥利用率、降低化肥使用量和減少農(nóng)藥的使用等方面,具有廣闊的應(yīng)用前景。通過(guò)施加復(fù)合強(qiáng)化菌劑改良土壤微生物生態(tài)平衡,減少化肥農(nóng)藥使用量,起到“減施增效” 功能。同時(shí)以菌治菌,通過(guò)強(qiáng)大的微生物活菌制劑抑制和殺死病原微生物,綠色,環(huán)保,減少化學(xué)農(nóng)藥帶來(lái)的一系列問(wèn)題,而且安全、有效和持久。